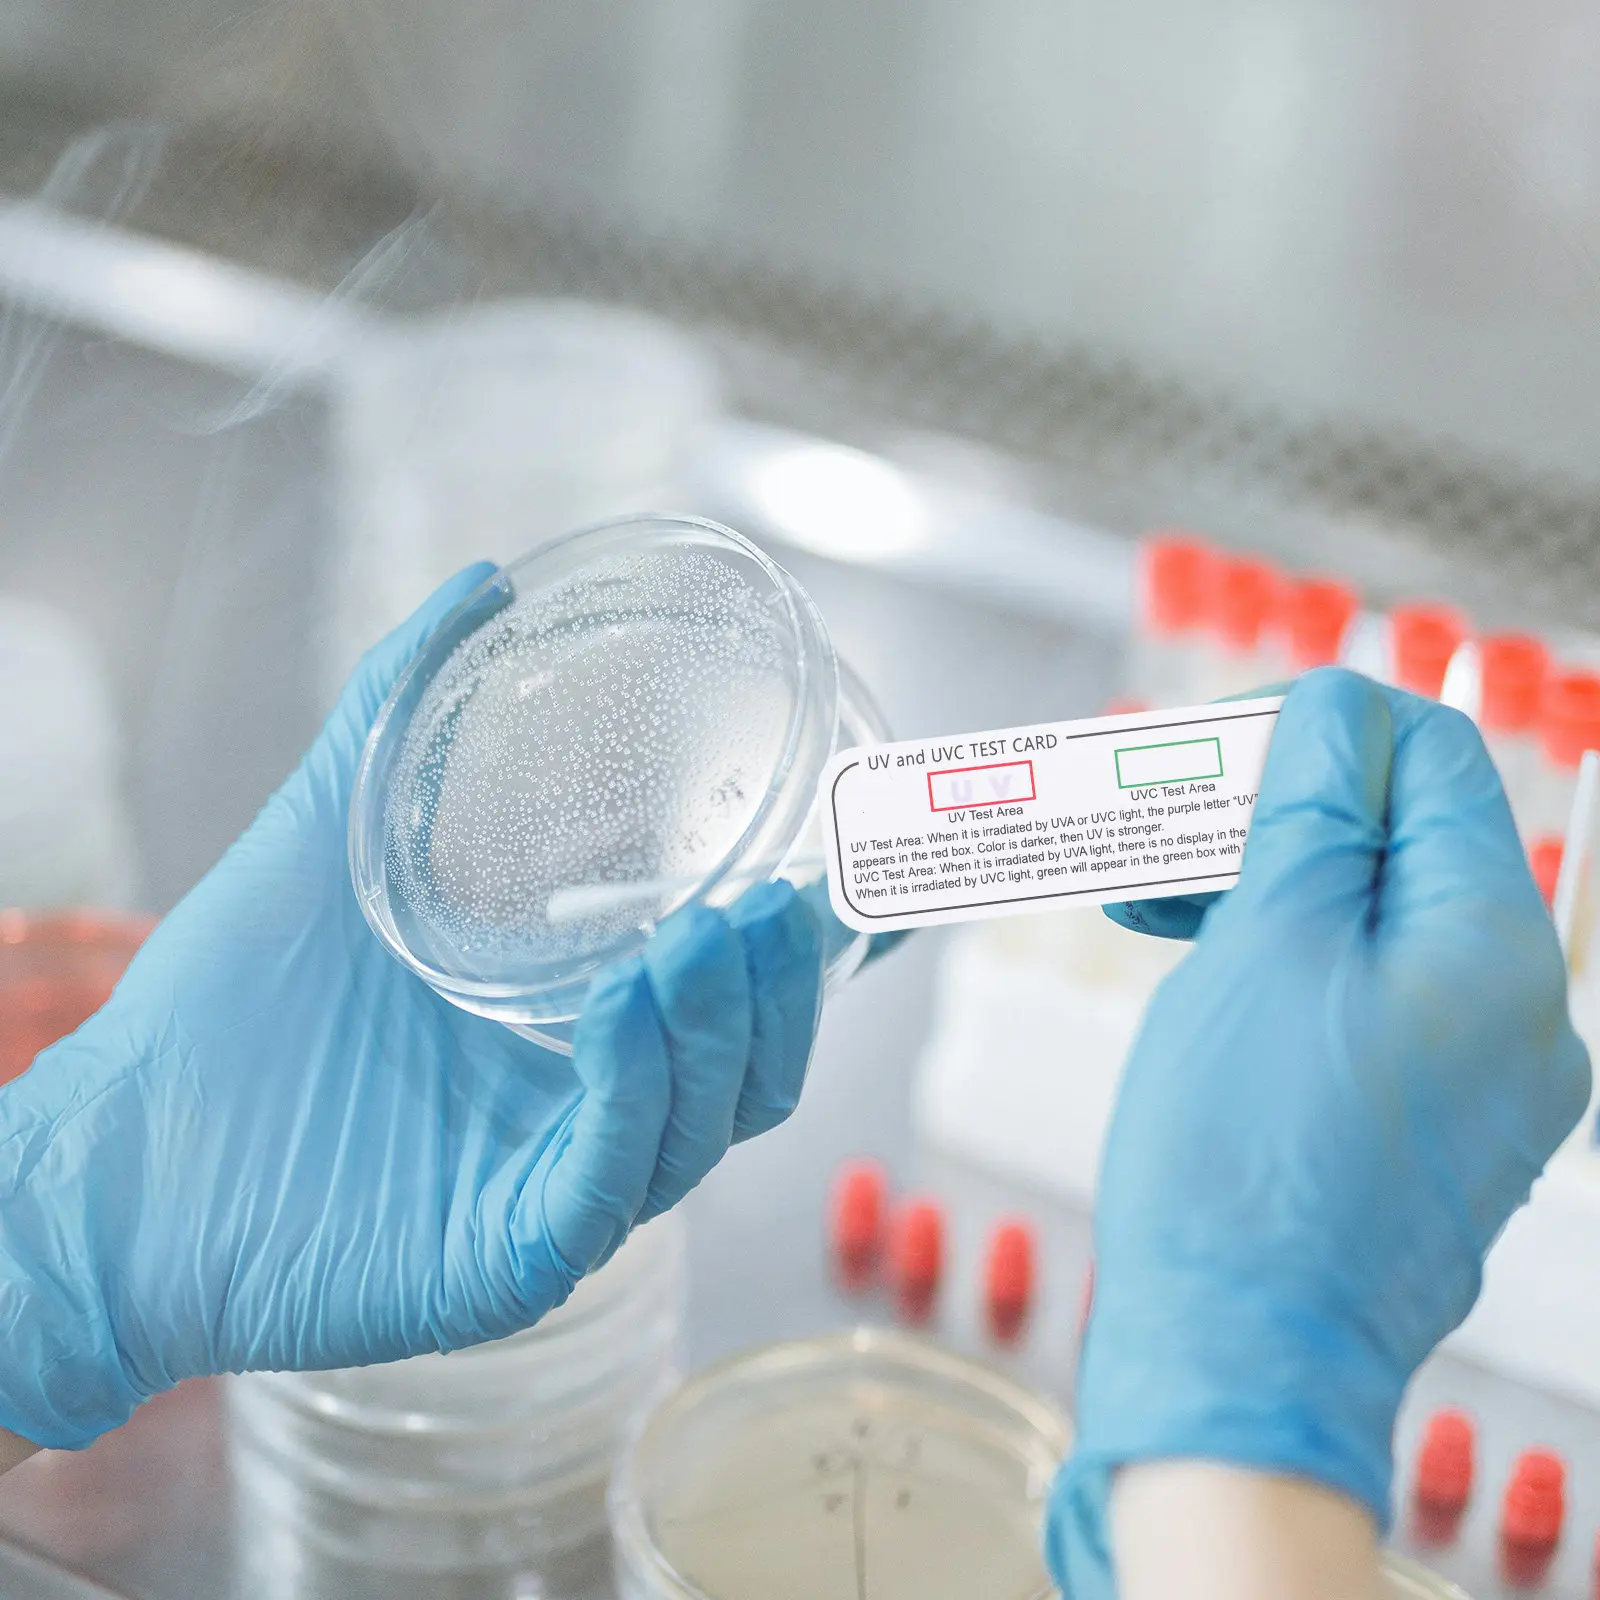
thumb

20Pcs Uvc Test Papers Uv Identifying Cards for Sterilizer Light Detection Clear Indicator Strips Reliable Performance in
Customers also viewed

$2.13
1 шт. 25-50HF120 25-85A 1200 в высокомощный выпрямитель, анод, крепление, диод, выпрямитель, металлический тип, выпрямитель, диоды, аксессуары
aliexpress.ru
$9.07
Для набора стеклорезов для плитки с длинной ручкой, чтобы увеличить эффективность силы во время использования. Полный пакет аксессуаров.
aliexpress.ru
$1.32
8 шт. противоскользящее кольцо для ракетки, захваты для бадминтона, теннисных ракеток, удобные кольца, сменные накладки, силиконовые ремешки
aliexpress.ru
$40.16
Коврики для Mazda CX-5 CX5 CX 5 MK2 2024 2023 2022 2021 2020 2019 2018 2017, автомобильные коврики, детали интерьера, водонепроницаемые чехлы
aliexpress.com
$356.91
Guarnieri 'del Gesu' 1742 "Lord Wilton"Violin Violino Copy "All European Wood",Oil Varnish!Performance Violin 4/4!Free Shipping
aliexpress.com
$20.45
Натуральный аметист кварц кластера кристаллами стеклянная бутылка желаний целебные камни рейки украшение дома для подарков
aliexpress.ru
$19.79
Размеры 16-30; Детские зимние ботинки; От 1 до 3 лет; Зимняя детская хлопковая обувь; Плюшевые теплые ботинки для девушек; Прогулочная обувь для малышей
aliexpress.ru
$336.43
New Model Digital Pet Heat Transfer Film Printer Pet Film Dryer Dtf Printer 60cm L1119
aliexpress.com
$28.38
Women Solid Color Threaded V-Neck T-Shirt 2023 Summer New Ladies Short Sleeve Lace Trim Stitching Single Breasted Slim Tee Tops
aliexpress.com
$35.52
SuperAen European and American Style Women's Clothing New 2023 Fashion Casual Belt Windbreaker Coat
aliexpress.com
$1.73
Оригинальная гнездовая розетка mini USB 10 шт./лот, Сделано в Тайване, гнездо mini USB, мини USB 5 пФ, 90 градусов, изогнутая ножка
aliexpress.ru
$2.45
Акция! Черная резина, 10 шт., 27 мм, фотоприсоска для аквариума, насоса для аквариума
aliexpress.ru
$10.84
5 шт. 101 мм 4 дюйма Т-образный хвостовик Jigsaw лезвия с алмазным напылением "zheijang ningbo" для кусконарезателя кладки гранит для резки плитки Мощность инструменты аксессуары
aliexpress.ru
$24.90
LINGGE High Quality Men Shoes Fashion Leather Boots Handmade Breathable Lightweight Men Ankle Shoes Casual Shoes Big Size 38-48
aliexpress.ru
$7.00
Ribbons Harem Joggers Men Cargo Pants Streetwear 2020 Hip Hop Casual Pockets Track Pants Male Harajuku Fashion Trousers
aliexpress.com
$30.62
Набор La Redoute, Разноцветный, Из четырех хлопковых пижам для детей от 18 мес. - 81 см разноцветный
laredoute.ru
$29.85
Женская зимняя водолазка свитер нижняя часть Hundred Plus Fluffy Models утолщенные свободные повседневные трикотажные топы с длинными рукавами M темно-коричневого
joom.com
$15.51
Силиконовые шапочки для плавания для мальчиков и девочек, милые шапочки для плавания с героями мультфильмов, удобная защита ушей, детская шапочка для плавания, аксессуары для бассейна розовый
joom.com
$9.71
Мужские трусы-боксеры из чистого хлопка, 2 шт., спортивные, удобные и дышащие, модные мужские шорты-боксеры с четырьмя углами
aliexpress.ru